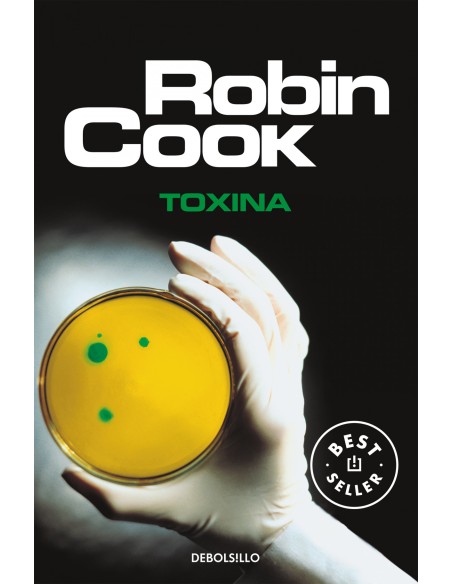
Toxina

Carrito
No hay más artículos en su carrito
Toxina
Kim Reggis, un famoso cirujano cardiovascular, lleva a su hija Becky a cenar la típica hamburguesa con patatas fritas, sin imaginarque este acto cotidiano cambiará su vida para siempre. En los días siguientes, Becky enfermerá gravemente a causa de una intoxicación producida por una bacteria letal. Desesperado ante el destino inexorable de su hija y a riesgo de su propia vida, Kim decide investigar las causas de la extraña enfermedad, lo que le conducirá por un laberinto de intereses que anteponen los beneficios económicos al juramento hipocrático, y que salpican hasta las más altas instancias gubernamentales...
- paginas
- 1
- encuadernacion
- OTRO FORMATO LIBRO
- espesor
- 21
- colección
- COOK, ROBIN
- altura
- 190
- ancho
- 125
3 Artículos
9788497595087
No hay comentarios